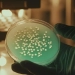

Francisco A. Torres: “En el sistema de pensiones no existen las cuentas inactivas, si no afiliados que no están cotizando”
Santo Domingo, Rep. Dom.- Francisco A. Torres, superintendente de Pensiones, aclaró que en el sistema de pensiones no existen las cuentas inactivas, lo que existen son afiliados que no están cotizando, es decir, que todas las cuentas se manejan de manera activa.
Durante la participación del superintendente de Pensiones en el Podcast que produce el periódico el Nuevo Diario, bajo la conducción de los periodistas Persio Maldonado y Ana Mercy Otáñez, Torres precisó que en el sistema de pensiones hay personas que no están cotizando hoy, pero, mañana si, por tal razón, todas las cuentas se manejan de manera activa.
“De la única manera que las cuentas no están activas es cuando ya están en cero, porque inclusive, en el momento de pensión, va a estar activa porque seguirá creciendo, aunque le estés sacando el dinero”.
Asimismo, reiteró que, aunque la Superintendencia de Pensiones no es hacedora de políticas públicas, sí es un agente investigador y de hecho organizó el debate realizado recientemente con representantes del Banco Mundial y la Conferencia Interamericana de Seguridad Social (CISS) con el apoyo de la Fundación Institucionalidad y Justicia (Finjus).
Además, “hemos tratado de incorporar la mayor parte de experiencias posibles para analizar el tema de las pensiones y así ir mejorando ciertos entuertos que hemos visto en estos últimos años. La idea nuestra es que no hay una bala plateada, no hay una sola cosa que el país tiene que hacer para perfeccionar lo que tenemos”.
La Sipen reiteró que la visita al podcast del prestigioso medio es parte de la agenda educativa e informativa de la Superintendencia, con la intención de masificar las informaciones sobre las pensiones.
Fuente:
sipen.gob.do
Plugin Install : Subscribe Push Notification need OneSignal plugin to be installed.